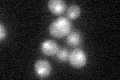

View description
Nuclear protein, possibly involved in regulation of cation stress responses and/or in the establishment of bipolar budding pattern
Localization:
Intensity:
Fold change:
Significance:
-
C’ GFP library in SD
nucleus24.1 -
N' NOP1pr-GFP in SD

N/A0 -
N' TEF2pr-mCherry in SD

N/A0 -
N' NATIVEpr-GFP in SD

N/A0 -
N' TEF2pr-VC and Cyto-VN in SD

N/A0 -
C’ GFP library in SD+DTT

nucleus18.890.78Yes -
C’ GFP library in SD+H2O2

nucleus19.950.82No -
C’ GFP library in Starvation Media

nucleus16.610.68Yes -
C’ GFP library on the background of Pup2-DaMP

nucleus -
C’ GFP library on the background of CCT mutant

nucleus22.85120.947681No
